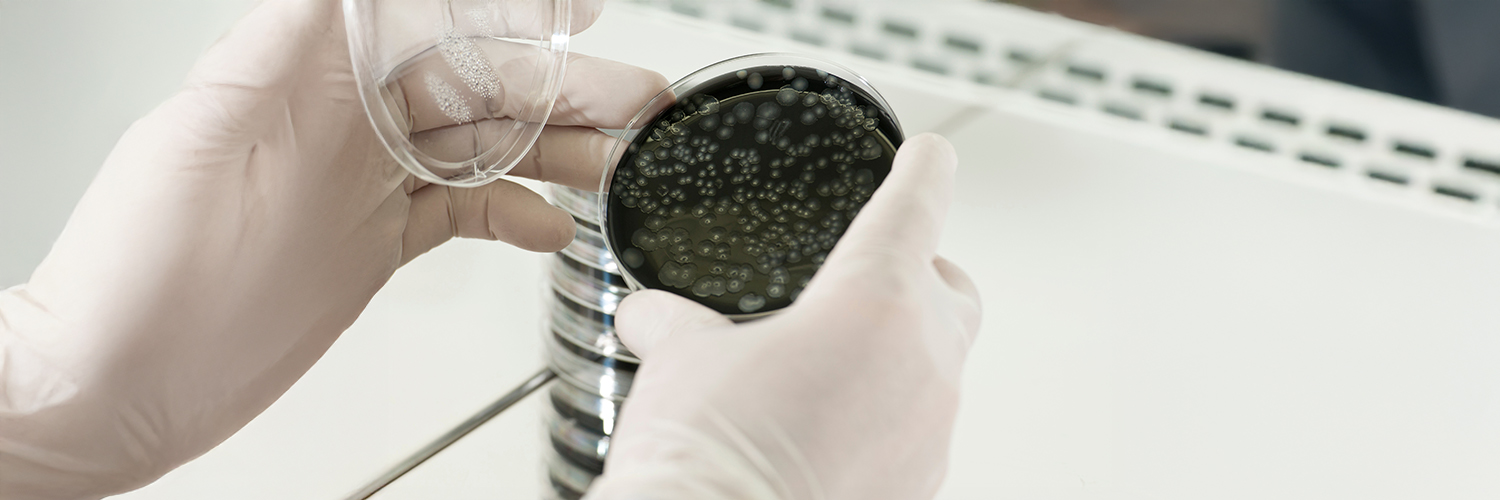
© Adobe Stock - Diego Calvi Culture bactérienne

FR
Les prélèvements sur eaux propres s’effectuent généralement pour réaliser des analyses microbiologiques. L’eau destinée à la consommation humaine ne doit pas nuire à la santé des consommateurs, elle doit donc être exempte de tout micro-organisme pathogène.
Il existe deux grandes familles de prélèvements :
Tous ces prélèvements sont effectués techniquement par le biais d’un prélèvement ponctuel, en respectant de multiples règles et précautions, afin d’éviter toute contamination de l’échantillon recueilli.
Les prélèvements sont réalisés par les préleveurs de CTC sous accréditation COFRAC.
La périodicité de ces contrôles dépend du classement de l’installation ou de sa catégorie, ainsi que des résultats des mesures précédentes. En général, un contrôle annuel est effectué, tandis que pour les TAR, ce contrôle peut dans certains cas être mensuel.
Deux types de structures sont concernés par les prélèvements pour analyses microbiologiques :
L’objectif des prélèvements et analyses des eaux de consommation est de rechercher la présence de micro-organismes (bactéries, virus et parasites). Cela permet de vérifier la qualité du traitement de désinfection et de garantir une utilisation de l'eau sans risque pour le consommateur.
La présence de micro-organismes dans l’eau de consommation peut engendrer un risque à court terme pour le consommateur, bien que le tableau clinique des pathologies engendrées soit généralement bénin pour la population générale (troubles gastro-intestinaux, diarrhées, etc.).
L’objectif des prélèvements et analyses légionelles est de rechercher la présence de légionelles dans les installations dans lesquelles la prolifération de ces bactéries est possible, notamment dans :
L’arrêté du 11 janvier 2007, relatif au programme de prélèvements et d’analyses du contrôle sanitaire pour les eaux fournies par un réseau de distribution, fixe les fréquences de prélèvement à respecter :
Pour les établissements recevant du public, l’arrêté du 1ᵉʳ février 2010 relatif à la surveillance des légionelles dans les installations de production, de stockage et de distribution d’eau chaude sanitaire, impose une fréquence annuelle de prélèvement.
Pour les industriels, les arrêtés du 14 décembre 2013 précisent que la fréquence est respectivement bimensuelle (tous les deux mois), et mensuelle pour les installations soumises au régime de l’enregistrement.
Cette prestation d'évaluation de la toxicité est destinée à l'analyse des effluents dans le cadre de la Directive cadre sur l'eau, en conformité avec les arrêtés du 21 décembre 2007 et du 20 mars 2015.
L'écotoxicologie se concentre sur l'impact des polluants toxiques sur les écosystèmes, tels que les pesticides et les polychlorobiphényles (PCB).
L'utilisation des daphnies permet d'obtenir rapidement des données sur la toxicité des différents polluants présents dans l'eau, en particulier ceux capables d'inhiber le développement ou l'activité des organismes aquatiques.
Ce test met en évidence une toxicité aiguë, c'est-à-dire une toxicité à court terme.
Les résultats obtenus sont essentiels pour déterminer la concentration de toxicité en équitox par mètre cube. Cette mesure indique la quantité de toxicité dans 1 m³ d'eau qui immobilise 50 % des daphnies après 24 heures.
Cette valeur est essentielle pour établir les modalités de calcul des redevances liées à la pollution de l'eau.
La méthodologie de prélèvement varie en fonction de la typologie d’analyse à réaliser (D1, D2, P1, P2, RP ou RS).